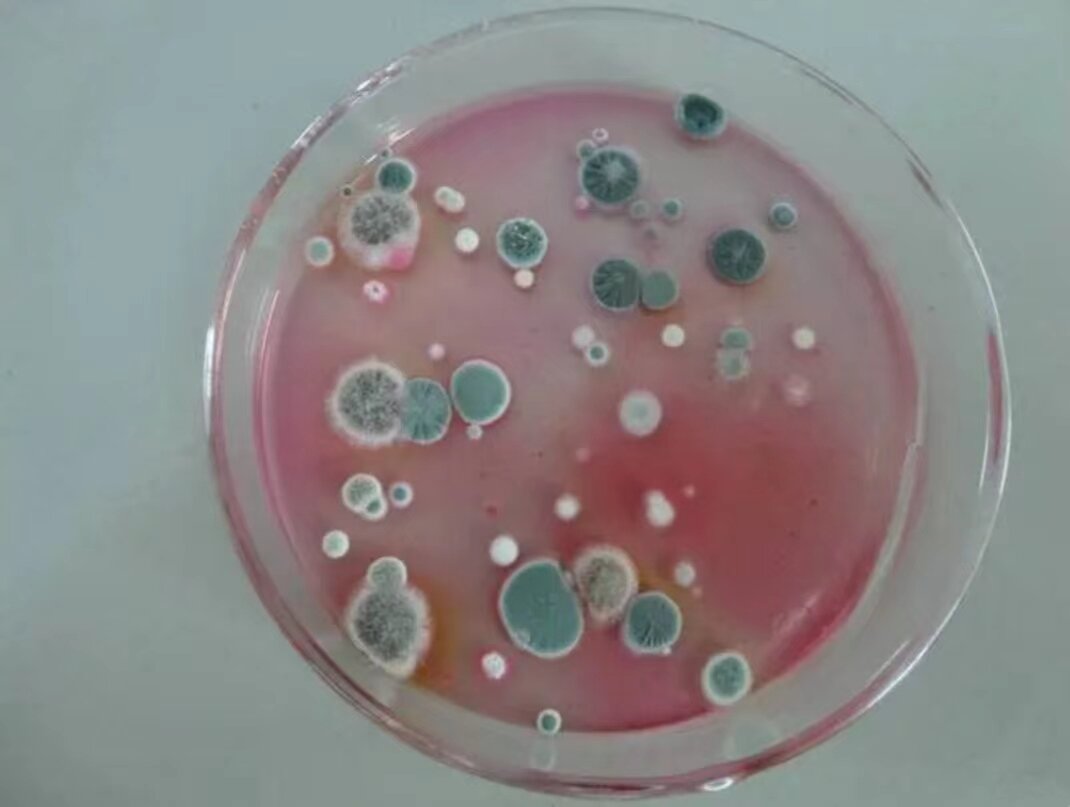
菌落简介及形态特征

菌落形态 常见

血平板上不同细菌菌落形态.#创作灵感 #微生物 #实验室 - 抖音
图片尺寸1920x1808
菌落总数
图片尺寸3024x4032
常见霉菌形态描述及典型菌落图片汇总!
图片尺寸660x664
图 各组材料菌落生长
图片尺寸1575x3302
白假丝酵母菌落形态及显微观察 一般我们看到酵母都椭圆形的圆乎乎的
图片尺寸960x1280
沙门氏菌菌落及菌体图片_牧医图谱_ 阳光畜牧网-畜牧养殖-动物保健
图片尺寸601x1404
请问前辈们这是什么菌落呢?
图片尺寸2938x3917
微生物检验常见三种大肠埃希菌菌落形态.#大肠埃希菌 #医学 - 抖音
图片尺寸984x1347
乳酸菌菌落形态及镜检图片
图片尺寸3780x1518
啤酒检测中常见的微生物菌落形态 - 知乎
图片尺寸1080x993
几类菌的菌落特征
图片尺寸590x782
啤酒检测中常见的微生物菌落形态_典型_特征_沙门氏菌
图片尺寸1080x1109
微生物菌落形态特征辨别
图片尺寸1840x3264
接下来,我们详细介绍一下四大类微生物中的常见微生物菌落形态:首先
图片尺寸583x345
白假丝酵母菌落形态及显微观察 一般我们看到酵母都椭圆形的圆乎乎的
图片尺寸960x1280
霉菌菌落
图片尺寸1180x1100
培养皿上的细菌菌落
图片尺寸1162x1100
金黄色葡萄球菌微生物菌落形态特征_典型_细胞_外观
图片尺寸900x596
菌落简介及形态特征
图片尺寸1070x807
毕赤酵母转化菌落形态求助
图片尺寸2098x2796